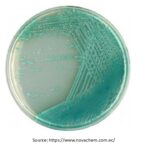
Pseudomonas agar: Introduction, Principle, Composition, Preparation, Procedure, Colony Morphology, Uses and Keynotes

Tag: Keynotes on Pseudomonas agar
Pseudomonas agar: Introduction, Principle, Composition, Preparation, Procedure, Colony Morphology, Uses and Keynotes
Introduction of Pseudomonas agar Pseudomonas agar is clear from its...
Introduction of Pseudomonas agar Pseudomonas agar is clear from its...
Cetrimide Agar: Introduction, Principle, Composition, Preparation, Procedure, Colony Morphology, Uses and Keynotes
 Introduction of Cetrimide Agar Cetrimide agar is a selective medium...
Introduction of Cetrimide Agar Cetrimide agar is a selective medium...
